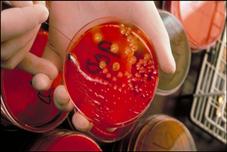

Health
Ijunoon
Mouzou Taskhees Or Bar Waqt Ilaj Dipression Se Nijat
جرمنی کی آٹھ کروڑ بیس لاکھ کی آبادی میں سے چالیس لاکھ کے قریب ڈپریشن کے مرض میں مبتلا ہیں مگر ان میں سے صرف معمولی تعداد کی ضروری علاج تک رسائی ہے۔
ماہرین کا کہنا ہے کہ اگرچہ اس مرض کے نتیجے میں...
مزید پڑھیں
Ijunoon
Aids K Liye Jadeed Adviaat Zindagi Ki Umeed
ایک جائزے کے مطابق برطانیہ میں ایچ آئی وی یعنی ایڈز کے مرض کے لیے بننے والی جدید ادویات سے گذشتہ دہائی کے دوران مریضوں میں زندگی کی امید بڑھی ہے۔
برطانیہ کے محققین نے اپنی رپورٹ میں کہا ہے کہ حکومت...
مزید پڑھیں
Ijunoon
Loban Alovera Or Ananas Ortharites Me Qudrat Ka Atiya
آرتھرائٹس (جوڑوں کے درد) میں لوبان، ایلوویرا اور انناس قدرت کا عطیہ ہیں۔ برصغیر میں پیدا ہونے والا لوبان جوڑوں کے درد کیلئے انتہائی مفید ثابت ہوا ہے یہ ایک مخصوص درخت سے حاصل ہونے والی خوشبودار گوند ہ...
مزید پڑھیں
Ijunoon
Izafi Vitimans Zindagi K Liye Khatra
محققین کا کہنا ہے کہ وٹامن صرف اسی صورت میں استعمال کیے جانے چاہیے جب جسم میں ان کی کمی ہو بصورتِ دیگر یہ نقصانِ دہ ہو سکتے ہیں۔
محققین کہتے ہیں کہ بات جب وٹامن کی آتی ہے تو بظاہر ایسا لگتا ہے کہ ک...
مزید پڑھیں
Ijunoon
Bachoon Ko Sehat Mand Khana Kaise Khelaya Jay
ایک نئی امریکی تحقیق کے مطابق بچوں کے پسندیدہ کھانوں میں سبزیاں اس طرح شامل کی جانی چاہییں کہ وہ باریک کٹی ہوئی ہوں اور بچوں کو پتہ بھی نہ چلے۔ اس طرح بچے کھانا بھی زیادہ کھاتے ہیں اور صحت مند بھی رہت...
مزید پڑھیں
Ijunoon
Ispreen Ka Mustaqil Istamal Binaye K Liye Khatra
ایک یورپی ریسرچ ادارے کے مطابق وہ معمر افراد جو روزانہ اسپرین کی ایک گولی لیتے ہیں، اُن افراد کے مقابلے میں بینائی میں کمی کے خطرے کے دوگنا زیادہ شکار ہوتے ہیں جو کبھی درد دور کرنے کی دوا نہیں لیتے۔
...
مزید پڑھیں
Ijunoon
Bair Hayateen Jeem Ka Khazana
بیر کا پھل دنیا کے بہت سے ممالک میں پایا جاتا ہے جن میں چین، آسٹریلیا، پاکستان، بھارت اور شام سرفہرست ہیں۔ بیر میں غذائی اعتبار سے حیاتین الف، ب اور ج کافی مقدار میں پائے جاتے ہیں۔ اس میں حیاتین ج کی ...
مزید پڑھیں
Ijunoon
Ziabaties K Natije Me Yaaddasht Pr Manfi Asraat
محققین کا کہنا ہے کہ ذیابیطس کے دائمی مریضوں میں ادویات کے ذریعے خون میں شوگر کی سطح گھٹانے سے ان کے دماغ کا حصہ محفوظ رکھنے میں مدد ملتی ہے مگر اس سے یادداشت کی کمزوری کے عمل کو روکنے میں کوئی فرق ن...
مزید پڑھیں
Ijunoon
Coffe Zehani Dabbao Se Bachnay Ka Zariya
تحقیق سے ثابت ہوا ہے کہ روزانہ چار کپ کافی پینے والے لوگوں کی بہ نسبت کافی نہ پینے والوں کے مقابلے میں کم ذہنی دبا ؤکا شکار ہوتی ہیں۔ ہارورڈ اسکول برائے صحت عامہ کے ماہرین نے بتایا کہ کافی میں استعمال...
مزید پڑھیں

Sponored Video